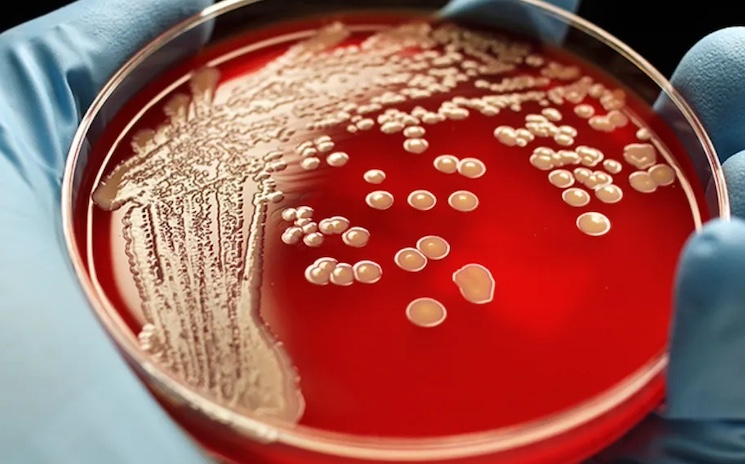
Super gonorrhea to be next pandemic out of China, CDC warns.

China is fuelling a global rise in ‘super gonorrhea’ – a new infectious disease that is set to become the next pandemic, according to the CDC.
98 percent of bacteria samples taken from patients with the STD across 13 Chinese provinces sidestepped frontline antibiotics, according to a new CDC report.
Endtimeheadlines.org reports: Gonorrhea had been effectively evading medications for years, but the chief worry among researchers is that China is reporting rates of a strain resistant to one of the last remaining effective antibiotics 40 times higher than those in the US, UK, and Canada.
Gonorrhea-causing bacteria have excelled at working around antibiotics, so much so that the only remaining recommended treatment is ceftriaxone.
In 2022, researchers affiliated with the CDC in China collected more than 2,800 bacteria samples from patients with gonorrhea.
Over 97 percent of the samples were resistant to the drug ciprofloxacin, commonly known as Cipro, while 78 percent resisted treatment with penicillin, another ubiquitous antibiotic.
Roughly 17 percent of samples were resistant to azithromycin and cefixime, while eight percent were immune to the current standard of care, ceftriaxone.
The percentage of gonorrhea bacteria strains resistant to ceftriaxone has risen from 2.9 percent to 8.1 percent, which is much higher than what is reported in other countries.
For instance, in the UK in 2022, only 0.21 percent of strains showed reduced susceptibility to ceftriaxone.
CDC data showed that in the US, only about 0.2 percent of strains had higher resistance to ceftriaxone between 2016 and 2020.
In Canada, from 2017 to 2021, the rate of resistance to ceftriaxone stayed relatively stable at about 0.6 percent.
The researchers said: ‘These findings underscore the urgent need for a comprehensive approach to address antibiotic-resistant N. gonorrhoeae in China, including identifying factors contributing to this high resistance rate.’
US investigates first two cases of super strength gonorrhea The cases were detected in Massachusetts. There is no connection between them. Dr Margaret Cooke, state health officer, said the strain posed a ‘serious public health concern’.
China was only the second country to document a case of ceftriaxone-resistant gonorrhea in 2016, after Japan identified one in 2009.
With rates of antibiotic resistance on the rise, new drugs to fight infections will always be needed. Gonorrhea is spread via sexual contact with the penis, vagina, mouth, or anus of an infected partner.
It can also be spread perinatally from mother to baby during childbirth. In most cases, it’s not a deadly conditition though if left untreated can become a more severe inflammatory issue leading to pain in the pelvic area and even infertility.
Historically, penicillin has been the first-line treatment, but due to widespread resistance, its use has dropped off.